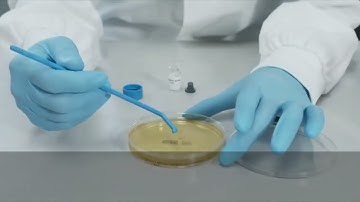
How to use BIOBALL® SINGLESHOT for on an agar plate?

⬇ DOWNLOAD NOW
Kalau muncul iklan pop-up, tutup lalu klik tombol kembali
Download lagu How to use BIOBALL® MULTISHOT 550 with BIOBALL® re-hydratation fluid? secara gratis hanya untuk keperluan promosi. Dukung artis favorit kamu dengan membeli musik original di iTunes atau platform resmi lainnya.
 How to use BIOBALL® MULTISHOT 550 with BIOBALL® 14-Day re-hydratation fluid?
How to use BIOBALL® MULTISHOT 550 with BIOBALL® 14-Day re-hydratation fluid?
 How to use BIOBALL® MULTISHOT 10E8 with BIOBALL® Re-Hydration Fluid?
How to use BIOBALL® MULTISHOT 10E8 with BIOBALL® Re-Hydration Fluid?
 BioBall MultiShot 550 with 14 day Re Hydration Fluid
BioBall MultiShot 550 with 14 day Re Hydration Fluid
How to use BIOBALL® SINGLESHOT for on an agar plate?
How to use BIOBALL® SINGLESHOT for on an agar plate?
 Measuring Volume Flow
Measuring Volume Flow
 BIOBALL® - Where accuracy, precision, efficiency and consistency matters the most.
BIOBALL® - Where accuracy, precision, efficiency and consistency matters the most.
 Aquaponics: Biofilter Tank
Aquaponics: Biofilter Tank
 SCANRDI® - When you Need to Know Now
SCANRDI® - When you Need to Know Now